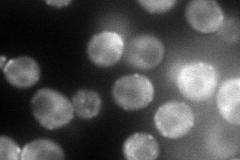
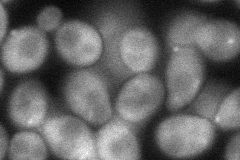

View description
Protein possibly involved in assembly of actin patches; interacts with an actin assembly factor Las17p and with the SH3 domains of Type I myosins Myo3p and Myo5p; localized predominantly to cortical actin patches
Localization:
Intensity:
Fold change:
Significance:
-
C’ GFP library in SD

below threshold18.71 -
N' NOP1pr-GFP in SD
punctate,bud132.922 -
N' TEF2pr-mCherry in SD

bud neck148.022 -
N' NATIVEpr-GFP in SD

punctate,bud neck36.6968 -
N' TEF2pr-VC and Cyto-VN in SD
cytosol,bud65.2224 -
C’ GFP library in SD+DTT

cytosol16.860.9No -
C’ GFP library in SD+H2O2

cytosol19.661.05No -
C’ GFP library in Starvation Media

cytosol16.80.89No -
C’ GFP library on the background of Pup2-DaMP

below threshold -
C’ GFP library on the background of CCT mutant

below threshold18.15120.970005No
